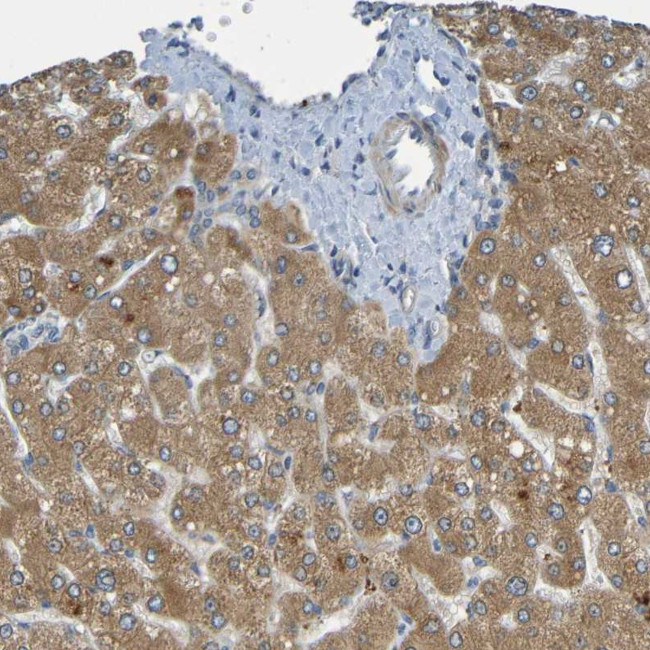
CYP4F2 Antibody in Immunohistochemistry (Paraffin) (IHC (P))

Search
Invitrogen
CYP4F2 Polyclonal Antibody
{{$productOrderCtrl.translations['antibody.pdp.commerceCard.promotion.promotions']}}
{{$productOrderCtrl.translations['antibody.pdp.commerceCard.promotion.viewpromo']}}
{{$productOrderCtrl.translations['antibody.pdp.commerceCard.promotion.promocode']}}: {{promo.promoCode}} {{promo.promoTitle}} {{promo.promoDescription}}. {{$productOrderCtrl.translations['antibody.pdp.commerceCard.promotion.learnmore']}}
产品信息
PA5-53117
种属反应
宿主/亚型
分类
类型
抗原
偶联物
形式
浓度
规格
纯化类型
保存液
内含物
保存条件
运输条件
RRID
产品详细信息
Immunogen sequence: RRNWFWGHQG MVNPTEEGMR VLTQLVATYP QGFKVWMGPI SPLLSLCHPD
Highest antigen sequence identity to the following orthologs: Mouse - 68%, Rat - 70%.
靶标信息
CYP4F isoforms are involved in the oxidation of important cellular mediators, such as leukotriene B4 (LTB4) and prostaglandins. CYP4F2 catalyzes omega-hydroxylation of LTB4 to a less potent proinflammatory eicosanoid, 20-OH-LTB4 as well as arachidonic acid. CYP4F2 is expressed in liver and kidney. Its expression is repressed by peroxisomal proliferators and induced by retinoic acid. X-linked adrenoleukodystrophy (X-ALD) is a severe neurodegenerative disorder biochemically characterized by elevated levels of very long-chain fatty acids (VLCFA). CYP4F2 participates in the omega-hydroxylation of VLCFAs, which may provide an alternative mode of treatment for X-ALD patients.
仅用于科研。不用于诊断过程。未经明确授权不得转售。
篇参考文献 (0)
生物信息学
蛋白别名: 20-HETE synthase; 20-hydroxyeicosatetraenoic acid synthase; Arachidonic acid omega-hydroxylase; CYPIVF2; Cytochrome P450 4F2; cytochrome P450, family 4, subfamily F, polypeptide 2; cytochrome P450, subfamily IVF, polypeptide 2; Cytochrome P450-LTB-omega; Docosahexaenoic acid omega-hydroxylase; Leukotriene-B(4) 20-monooxygenase 1; Leukotriene-B(4) omega-hydroxylase 1; Phylloquinone omega-hydroxylase CYP4F2; unnamed protein product
基因别名: CPF2; CYP4F2
UniProt ID: (Human) P78329
Entrez Gene ID: (Human) 8529